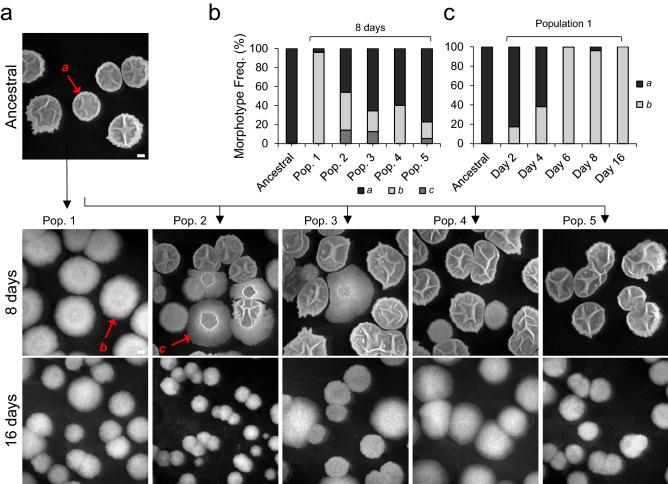
https://cdn.ncbi.nlm.nih.gov/pmc/blobs/850f/7642357/d13b843760f6/41598_2020_76017_Fig1_HTML.jpg

在枯草芽孢杆菌自然分离株的驯化过程中,社会特征的猖獗丧失。
Rampant loss of social traits during domestication of a Bacillus subtilis natural isolate.
机构信息
Instituto Gulbenkian de Ciência, Oeiras, Portugal.
Instituto de Tecnologia Química e Biológica António Xavier, Universidade Nova de Lisboa, Oeiras, Portugal.
出版信息
Sci Rep. 2020 Nov 3;10(1):18886. doi: 10.1038/s41598-020-76017-1.
Most model bacteria have been domesticated in laboratory conditions. Yet, the tempo with which a natural isolate diverges from its ancestral phenotype under domestication to a novel laboratory environment is poorly understood. Such knowledge, however is essential to understanding the rate of evolution, the time scale over which a natural isolate can be propagated without loss of its natural adaptive traits, and the reliability of experimental results across labs. Using experimental evolution, phenotypic assays, and whole-genome sequencing, we show that within a week of propagation in a common laboratory environment, a natural isolate of Bacillus subtilis acquires mutations that cause changes in a multitude of traits. A single adaptive mutational step in the gene coding for the transcriptional regulator DegU impairs a DegU-dependent positive autoregulatory loop and leads to loss of robust biofilm architecture, impaired swarming motility, reduced secretion of exoproteases, and to changes in the dynamics of sporulation across environments. Importantly, domestication also resulted in improved survival when the bacteria face pressure from cells of the innate immune system. These results show that degU is a target for mutations during domestication and underscores the importance of performing careful and extremely short-term propagations of natural isolates to conserve the traits encoded in their original genomes.
大多数模式细菌都是在实验室条件下驯化的。然而,对于一个自然分离株在驯化过程中从其祖先表型向新的实验室环境中分化的速度,人们知之甚少。然而,这种知识对于理解进化的速度、自然分离株在没有失去其自然适应性特征的情况下可以繁殖的时间尺度,以及实验室之间实验结果的可靠性是至关重要的。使用实验进化、表型分析和全基因组测序,我们表明,在常见的实验室环境中繁殖一周内,枯草芽孢杆菌的一个自然分离株就会获得导致多种性状变化的突变。基因编码转录调控因子 DegU 的单个适应性突变步骤会破坏 DegU 依赖的正反馈调节环,导致稳健生物膜结构的丧失、群集运动能力受损、外蛋白酶分泌减少,以及在不同环境中孢子形成的动力学发生变化。重要的是,驯化还导致细菌在面对先天免疫系统细胞的压力时提高了生存能力。这些结果表明,degU 是驯化过程中突变的靶标,并强调了仔细和极短期繁殖自然分离株以保存其原始基因组中编码的特征的重要性。